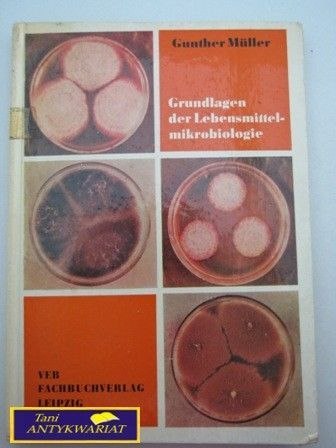
GRUNDLAGEN DER LEBENSMITTELMIKROBIOLOGIE

GRUNDLAGEN DER LEBENSMITTELMIKROBIOLOGIE
Symbol: 606157406
Dostępność:
Mało
1
szt.
Cena: 29.08